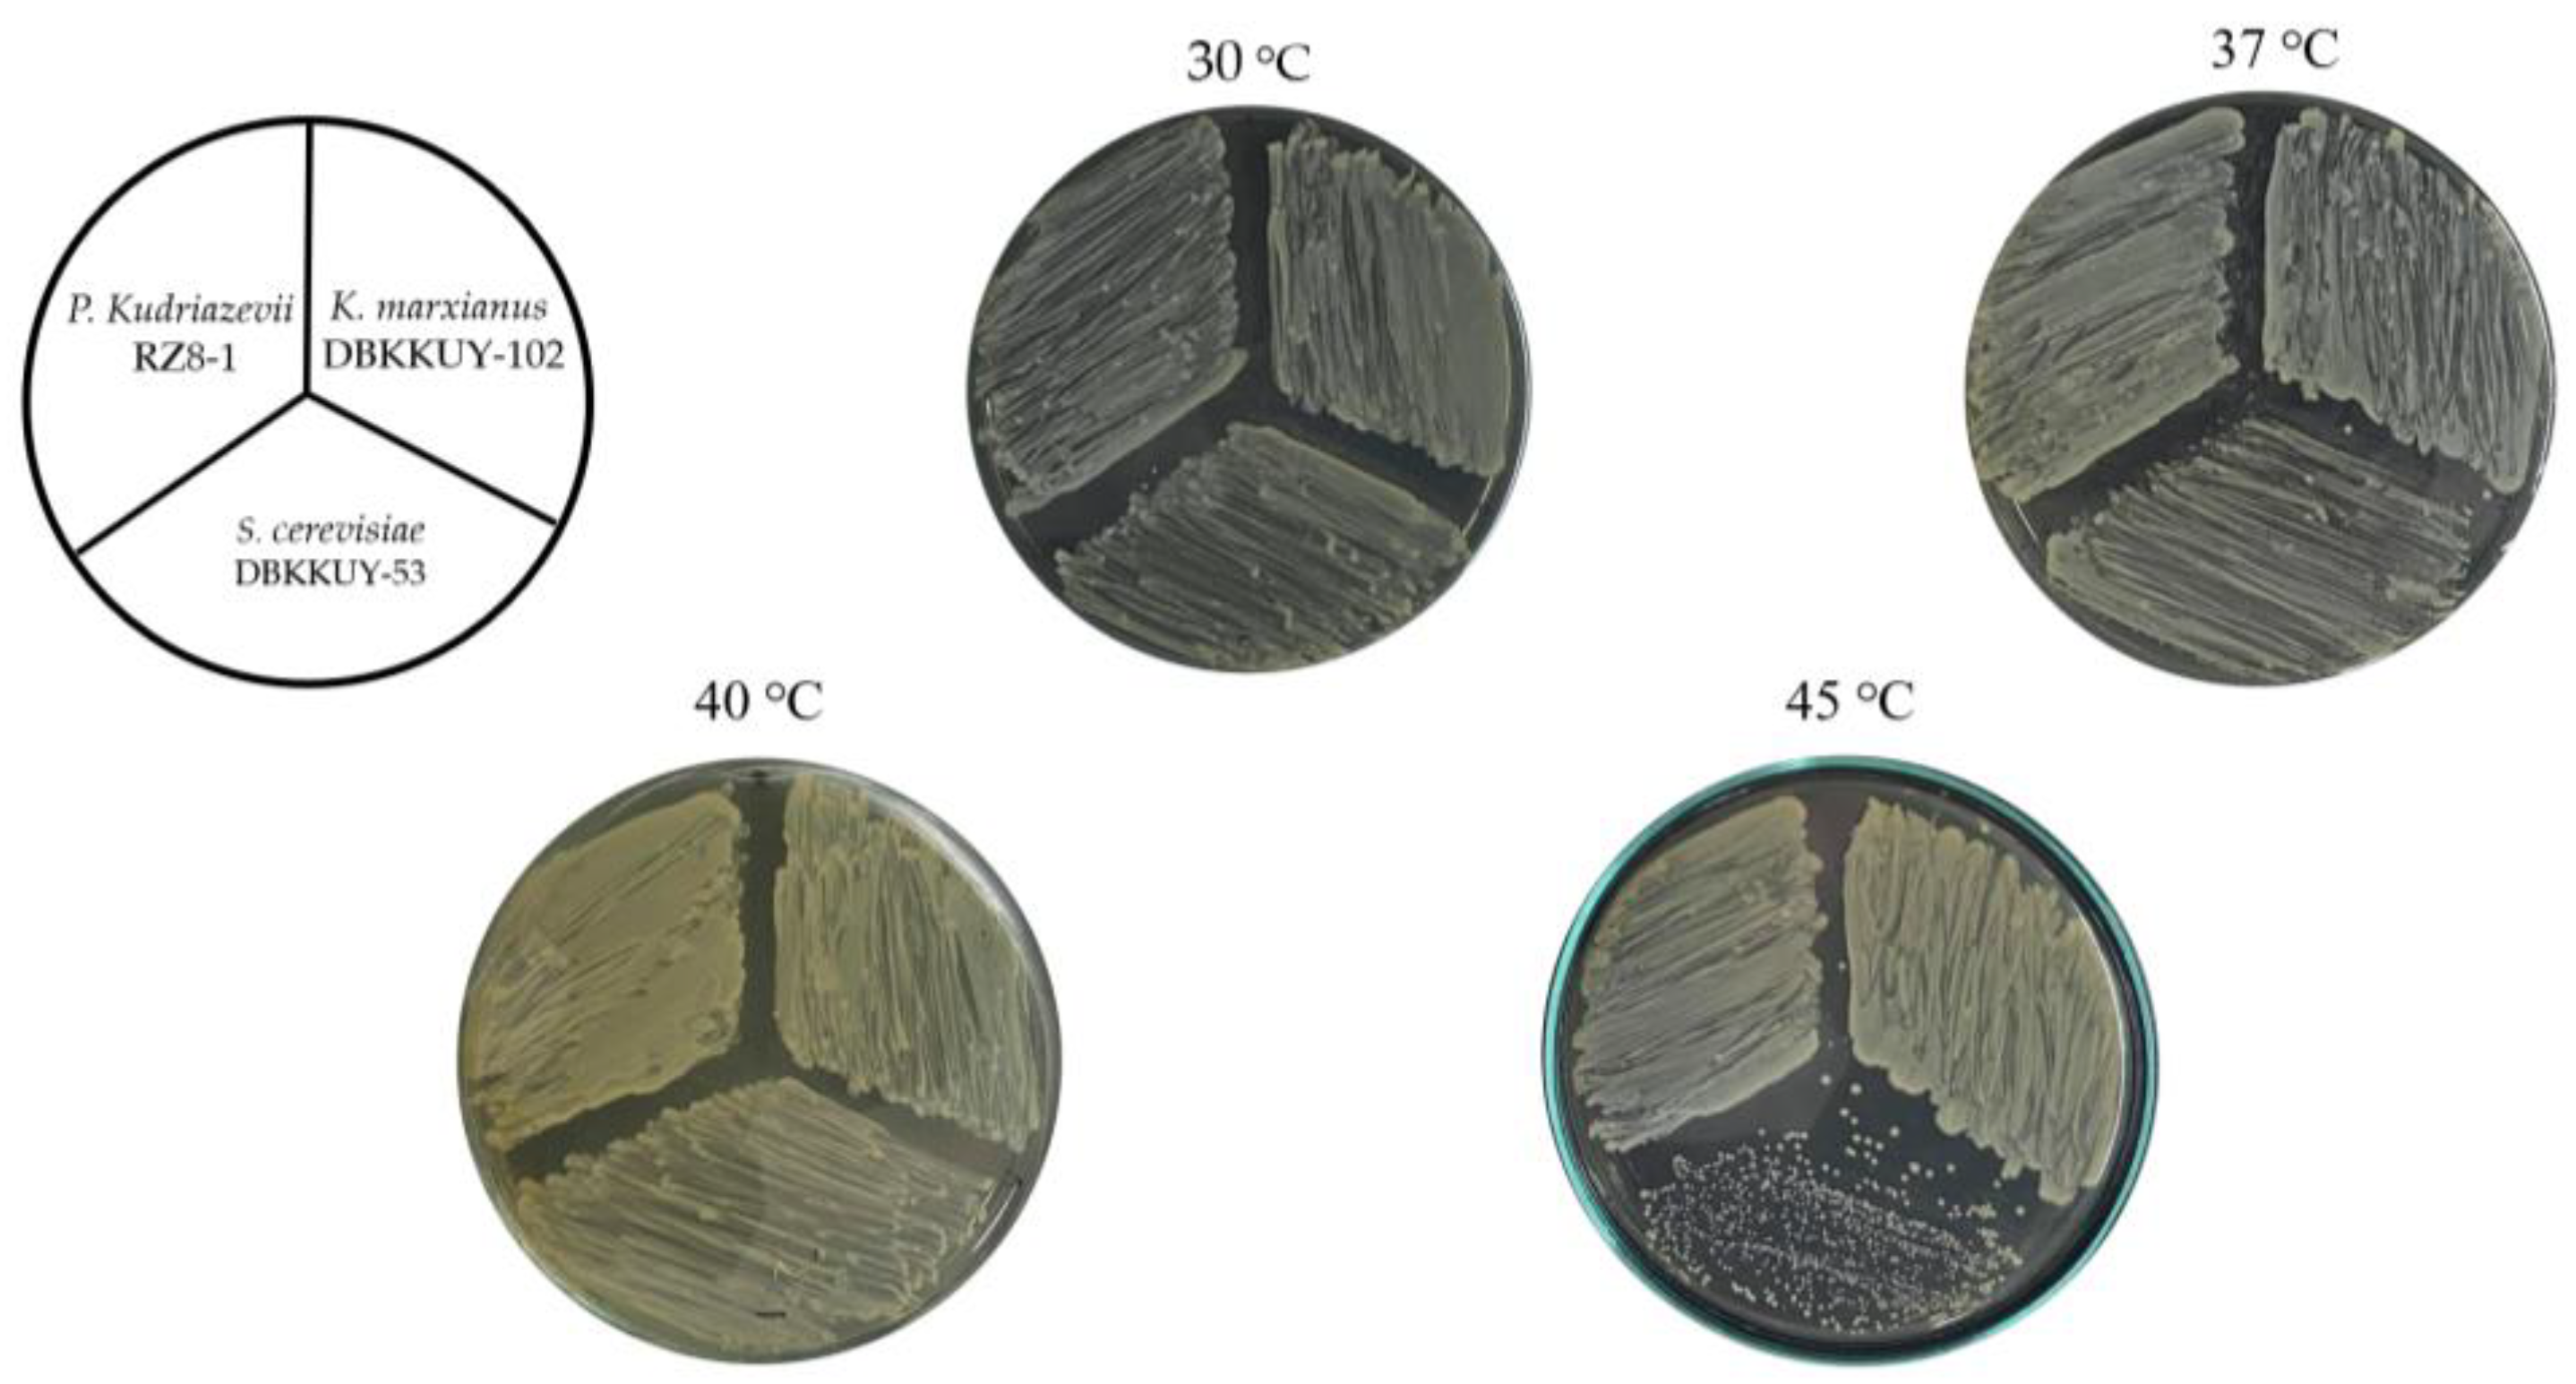
Processes 11 02920 g003

Exploring the Utilization Potential of Spirogyra sp. Biomass for Ethanol Production: A Study on Saccharification Optimization and High-Temperature Ethanol Fermentation
Abstract
:1. Introduction
2. Materials and Methods
2.1. Microorganisms and Culture Conditions
2.2. Biomass of Spirogyra sp.
2.3. Acid Hydrolysis and the Concentration of Spirogyra sp. Hydrolysate
2.4. Growth and Ethanol Tolerance of the Yeast Strains at High Temperatures
2.5. Ethanol Fermentation
2.6. Analytical Methods
3. Results and Discussion
3.1. Spirogyra sp. Biomass Compositions
3.2. Acid Hydrolysis of Spirogyra sp. Biomass
3.3. Growth and Ethanol Tolerance of the Yeast Strains at High Temperatures
3.4. Ethanol Fermentations
4. Conclusions
Author Contributions
Funding
Data Availability Statement
Acknowledgments
Conflicts of Interest
References
- Rasoulinezhad, E.; Taghizadeh-Hesary, F.; Taghizadeh-Hesary, F. How Is Mortality Affected by Fossil Fuel Consumption, CO2 Emissions and Economic Factors in CIS Region? Energies 2020, 13, 2255. [Google Scholar] [CrossRef]
- Kalair, A.; Abas, N.; Saleem, M.S.; Kalair, A.R.; Khan, N. Role of energy storage systems in energy transition from fossil fuels to renewables. Energy Storage 2020, 3, e135. [Google Scholar] [CrossRef]
- Friedlingstein, P.; O’Sullivan, M.; Jones, M.W.; Andrew, R.M.; Gregor, L.; Hauck, J. Global carbon budget 2022. ESSD 2022, 14, 4811–4900. [Google Scholar] [CrossRef]
- Lelieveld, J.; Klingmüller, K.; Pozzer, A.; Burnett, R.T.; Haines, A.; Ramanathan, V. Effects of fossil fuel and total anthropogenic emission removal on public health and climate. Proc. Natl. Acad. Sci. USA 2019, 116, 7192–7197. [Google Scholar] [CrossRef] [PubMed]
- Holechek, J.L.; Geli, H.M.E.; Sawalhah, M.N.; Valdez, R. A Global Assessment: Can Renewable Energy Replace Fossil Fuels by 2050? Sustainability 2022, 14, 4792. [Google Scholar] [CrossRef]
- Farrell, A.E.; Plevin, R.J.; Turner, B.T.; Jones, A.D.; O’Hare, M.; Kammen, D.M. Ethanol can contribute to energy and environmental goals. Science 2006, 311, 506–508. [Google Scholar] [CrossRef]
- Hill, J.; Nelson, E.; Tilman, D.; Polasky, S.; Tiffany, D. Environmental, economic, and energetic costs and benefits of biodiesel and ethanol biofuels. Proc. Natl. Acad. Sci. USA 2006, 103, 11206–11210. [Google Scholar] [CrossRef]
- Yan, J.; Lin, T. Biofuels in Asia. Appl. Energy 2009, 86, S1–S10. [Google Scholar] [CrossRef]
- Harun, R.; Danquah, M.K.; Forde, G.M. Microalgal biomass as a fermentation feedstock for bioethanol production. J. Chem. Technol. Biotechnol. 2009, 85, 199–203. [Google Scholar] [CrossRef]
- Thailand Alternative Energy Situation 2020 Report; Ministry of Energy: Bangkok, Thailand, 2020. Available online: https://webkc.dede.go.th/testmax/node/5735 (accessed on 1 March 2022).
- Rizza, L.S.; Smachetti, M.E.S.; Nascimento, M.D.; Salerno, G.L.; Curatti, L. Bioprospecting for native microalgae as an alternative source of sugars for the production of bioethanol. Algal Res. 2017, 22, 140–147. [Google Scholar] [CrossRef]
- El-Dalatony, M.M.; Kurade, M.B.; Abou-Shanab, R.A.I.; Kim, H.; Salama, E.-S.; Jeon, B.-H. Long-term production of bioethanol in repeated-batch fermentation of microalgal biomass using immobilized Saccharomyces Cerevisiae. Bioresour. Technol. 2016, 219, 98–105. [Google Scholar] [CrossRef] [PubMed]
- Demirbas, A. Biofuels sources, biofuel policy, biofuel economy and global biofuel projections. Energy Convers. Manag. 2008, 49, 2106–2116. [Google Scholar] [CrossRef]
- Odum, W.E.; Heald, E.J. Trophic analyses of an estuarine mangrove community. Bull. Mar. Sci. 1972, 22, 671–738. [Google Scholar]
- Ramachandra, T.V.; Madhab, M.D.; Shilpi, S.; Joshi, N.V. Algal biofuel from urban wastewater in India: Scope and challenges. Renew. Sustain. Energy Rev. 2013, 21, 767–777. [Google Scholar] [CrossRef]
- Harchi, M.E.; Kachkach, F.Z.F.; Mtili, N.E. Optimization of thermal acid hydrolysis for bioethanol production from Ulva rigida with yeast Pachysolen tannophilus. S. Afr. J. Bot. 2018, 115, 161–169. [Google Scholar] [CrossRef]
- Hamouda, R.A.; Sherif, S.A.; Ghareeb, M.M. Bioethanol production by various hydrolysis and fermentation processes with micro and macro green algae. Waste Biomass Valorization 2018, 9, 1495–1501. [Google Scholar] [CrossRef]
- Kim, S.W.; Hong, C.H.; Jeon, S.W.; Shin, H.J. High-yield production of biosugars from Gracilaria verrucosa by acid and enzymatic hydrolysis processes. Bioresour. Technol. 2015, 196, 634–641. [Google Scholar] [CrossRef]
- Alfonsín, V.; Maceiras, R.; Gutiérrez, C. Bioethanol production from industrial algae waste. Waste Manag. 2019, 87, 791–797. [Google Scholar] [CrossRef]
- Pinto, T.; Gouveia, L.; Ortigueira, J.; Saratale, G.D.; Moura, P. Enhancement of fermentative hydrogen production from Spirogyra sp. by increased carbohydrate accumulation and selection of the biomass pretreatment under a biorefinery model. J. Biosci. Bioeng. 2018, 126, 226–234. [Google Scholar] [CrossRef]
- Anyanwu, I.N.; Okeke, C.S.; Nwankwo, S.C.; Nwachukwu, M.O.; Michael, M.O.; Opara, V.C.; Anorue, C.O.; Azuama, O.C.; Oti, P.O.; Ekechukwu, L.E.; et al. Aquatic macrophytes (Spirogyra porticalis and Nymphaea L.) as substrates for biofuel production: Potentials and challenges. Sci. Afr. 2022, 18, e01412. [Google Scholar] [CrossRef]
- Ge, S.; Madill, M.; Champagne, P. Use of freshwater macroalgae Spirogyra sp. for the treatment of municipal wastewaters and biomass production for biofuel applications. Biomass Bioenergy 2018, 111, 213–223. [Google Scholar] [CrossRef]
- Becker, J.; Boles, E. A Modified Saccharomyces cerevisiae Strain That Consumes L-Arabinose and Produces Ethanol. Appl. Environ. Microbiol. 2003, 69, 4144–4150. [Google Scholar] [CrossRef] [PubMed]
- Kobayashi, M.; Kakizono, T.; Nishio, N.; Nagai, S.; Kurimura, Y.; Tsuji, Y. Antioxidant role of astaxanthin in the green alga Haematococcus Pluvialis. Appl. Microbiol. Biotechnol. 1997, 48, 351–356. [Google Scholar] [CrossRef]
- Aditiya, H.B.; Mahlia, T.M.I.; Chong, W.T.; Nur, H.; Sebayang, A.H. Second generation bioethanol production: A critical review. Renew. Sustain. Energy Rev. 2016, 66, 631–653. [Google Scholar] [CrossRef]
- Chen, C.Y.; Zhao, X.-Q.; Yen, H.-W.; Ho, S.-H.; Cheng, C.-L.; Lee, D.J.; Chang, J.-S. Microalgae-based carbohydrates for biofuel production. Biochem. Eng. J. 2013, 78, 1–10. [Google Scholar] [CrossRef]
- Abdel-Banat, B.M.A.; Hoshida, H.; Ano, A.; Nonklang, S.; Akada, R. High-temperature fermentation: How can processes for ethanol production at high temperatures become superior to the traditional process using mesophilic yeast? Appl. Microbiol. Biotechnol. 2009, 85, 861–867. [Google Scholar] [CrossRef]
- Nuanpeng, S.; Thanonkeo, S.; Yamada, M.; Thanonkeo, P. Ethanol Production from Sweet Sorghum Juice at High Temperatures Using a Newly Isolated Thermotolerant Yeast Saccharomyces cerevisiae DBKKU Y-53. Energies 2016, 9, 253. [Google Scholar] [CrossRef]
- Techaparin, A.; Thanonkeo, P.; Klanrit, P. High-temperature ethanol production using thermotolerant yeast newly isolated from Greater Mekong Subregion. Braz. J. Microbiol. 2017, 48, 461–475. [Google Scholar] [CrossRef]
- Chamnipa, N.; Thanonkeo, S.; Klanrit, P.; Thanonkeo, P. The potential of the newly isolated thermotolerant yeast Pichia kudriavzevii RZ8-1 for high-temperature ethanol production. Braz. J. Microbiol. 2018, 49, 378–391. [Google Scholar] [CrossRef]
- Phong, H.X.; Klanrit, P.; Dung, N.T.P.; Yamada, M.; Thanonkeo, P. Isolation and characterization of thermotolerant yeasts for the production of second-generation bioethanol. Ann. Microbiol. 2019, 69, 765–776. [Google Scholar] [CrossRef]
- Pilap, W.; Thanonkeo, S.; Klanrit, P.; Thanonkeo, P. The potential of multistress tolerant yeast, Saccharomycodes ludwigii, for second-generation bioethanol production. Sci. Rep. 2022, 12, 22062. [Google Scholar] [CrossRef] [PubMed]
- Charoensopharat, K.; Thanonkeo, P.; Thanonkeo, S.; Yamada, M. Ethanol production from Jerusalem artichoke tubers at high temperature by newly isolated thermotolerant inulin-utilizing yeast Kluyveromyces marxianus using consolidated bioprocessing. Antonie Van Leeuwenhoek 2015, 108, 173–190. [Google Scholar] [CrossRef] [PubMed]
- Latimer, G.W. Official Methids of Analysis of AOAC International, 21st ed.; AOAC International: Gaithersburg, MD, USA, 2019. [Google Scholar]
- Ge, L.; Wang, P.; Mou, H. Study on saccharification techniques of seaweed wastes for the transformation of ethanol. Renew. Energy 2011, 36, 84–89. [Google Scholar] [CrossRef]
- Mecozzi, M. Estimation of total carbohydrate amount in environmental samples by the phenol-sulphuric acid method assisted by multivariate calibration. Chemom. Intell. Lab. Syst. 2005, 79, 84–90. [Google Scholar] [CrossRef]
- Zoecklien, B.; Fugelsang, K.; Gump, B.; Nury, F. Wine Analysis and Production; Chapman & Hall: New York, USA, 1995. [Google Scholar]
- Laopaiboon, L.; Thanonkeo, P.; Jaisil, P.; Laopaiboon, P. Ethanol production from sweet sorghum juice in batch and fed-batch fermentations by Saccharomyces cerevisiae. World J. Microbiol. Biotechnol. 2007, 23, 1497–1501. [Google Scholar] [CrossRef]
- Sudhakar, M.P.; Merlyn, R.; Arunkumar, K.; Perumal, K. Characterization, pretreatment and saccharification of spent seaweed biomass for bioethanol production using baker’s yeast. Biomass Bioenergy 2016, 90, 148–154. [Google Scholar] [CrossRef]
- Soliman, R.M.; Younis, S.A.; El-Gendy, N.S.; Mostafa, S.S.M.; El-Temtamy, S.A.; Hashim, A.I. Batch bioethanol production via the biological and chemical saccharification of some Egyptian marine macroalgae. J. Appl. Microbiol. 2018, 125, 422–440. [Google Scholar] [CrossRef]
- Lu, Y.; Wang, Y.; Xu, G.; Chu, J.; Zhuang, Y.; Zhang, S. Influence of High Solid Concentration on Enzymatic Hydrolysis and Fermentation of Steam-Exploded Corn Stover Biomass. Appl. Biochem. Biotechnol. 2008, 160, 360–369. [Google Scholar] [CrossRef]
- Zhao, S.; Li, P.; Zhang, Q.; Zhang, J.; Kong, L. Production of reducing sugar from corn stover by dilute acid hydrolysis co-catalyzed with metal salts under microwave radiation. Res. Chem. Intermed. 2012, 39, 3803–3812. [Google Scholar] [CrossRef]
- Poespowati, T.; Mahmudi, A. Optimization of acid hydrolysis process on macroalgae Ulva lactuca for reducing sugar production as feedstock of bioethanol. Int. J. Renew. Energy Res. 2018, 8, 466–473. [Google Scholar]
- Ikegaya, H.; Hayashi, T.; Kaku, T.; Iwata, K.; Sonobe, S.; Shimmen, T. Presence of xyloglucan-like polysaccharide in Spirogyra and possible involvement in cell-cell attachment. Phycol. Res. 2008, 56, 216–222. [Google Scholar] [CrossRef]
- Świątek, K.; Gaag, S.; Klier, A.; Kruse, A.; Sauer, J.; Steinbach, D. Acid Hydrolysis of Lignocellulosic Biomass: Sugars and Furfurals Formation. Catalysts 2020, 10, 437. [Google Scholar] [CrossRef]
- Feng, D.; Liu, H.; Li, F.; Jiang, P.; Qin, S. Optimization of dilute acid hydrolysis of Enteromorpha. Chin. J. Oceanol. Limnol. 2011, 29, 1243–1248. [Google Scholar] [CrossRef]
- Hong, I.K.; Jeon, H.; Lee, S.B. Comparison of red, brown and green seaweeds on enzymatic saccharification process. J. Ind. Eng. Chem. 2014, 20, 2687–2691. [Google Scholar] [CrossRef]
- Sivagurunathan, P.; Kumar, G.; Kobayashi, T.; Xu, K.; Kim, S.-H. Effects of various dilute acid pretreatments on the biochemical hydrogen production potential of marine macroalgal biomass. Int. J. Hydrogen Energy 2017, 42, 27600–27606. [Google Scholar] [CrossRef]
- Hessami, M.J.; Cheng, S.F.; Ambati, R.R.; Yin, Y.H.; Phang, S.M. Bioethanol production from agarophyte red seaweed, Gelidium elegans, using a novel sample preparation method for analysing bioethanol content by gas chromatography. 3 Biotech 2019, 9, 25. [Google Scholar] [CrossRef] [PubMed]
- Kumar, V.; Nanda, M.; Joshi, H.C.; Singh, A.; Sharma, S.; Verma, M. Production of biodiesel and bioethanol using algal biomass harvested from fresh water river. Renew. Energy 2018, 116, 606–612. [Google Scholar] [CrossRef]
- Basso, L.C.; de Amorim, H.V.; de Oliveira, A.J.; Lopes, M.L. Yeast selection for fuel ethanol production in Brazil. FEMS Yeast Res. 2008, 8, 1155–1163. [Google Scholar] [CrossRef]
- Piper, P.W. Molecular events associated with acquisition of heat tolerance by the yeast Saccharomyces cerevisiae. FEMS Microbiol. Rev. 1993, 11, 339–355. [Google Scholar] [CrossRef]
- Bell, A.N.W.; Magill, E.; Hallsworth, J.E.; Timson, D.J. Effects of Alcohols and Compatible Solutes on the Activity of β-Galactosidase. Appl. Biochem. Biotechnol. 2012, 169, 786–794. [Google Scholar] [CrossRef]
- Sree, N.K.; Sridhar, M.; Suresh, K.; Banat, I.M.; Rao, L.V. Isolation of thermotolerant, osmotolerant, flocculating Saccharomyces cerevisiae for ethanol production. Bioresour. Technol. 2000, 72, 43–46. [Google Scholar] [CrossRef]
- Edgardo, A.; Carolina, P.; Manuel, R.; Juanita, F.; Baeza, J. Selection of thermotolerant yeast strains Saccharomyces cerevisiae for bioethanol production. Enzym. Microb. Technol. 2008, 43, 120–123. [Google Scholar] [CrossRef]
- Pongcharoen, P.; Chawneua, J.; Tawong, W. High temperature alcoholic fermentation by new thermotolerant yeast strains Pichia kudriavzevii isolated from sugarcane field soil. Agric. Nat. Resour. 2018, 52, 511–518. [Google Scholar] [CrossRef]
- Banat, I.M.; Nigam, P.; Marchant, R. Isolation of thermotolerant, fermentative yeasts growing at 52 °C and producing ethanol at 45 °C and 50 °C. World J. Microbiol. Biotechnol. 1992, 8, 259–263. [Google Scholar] [CrossRef] [PubMed]
- Negi, B.; Sharma, P.; Kashyap, S.; Seth, S.; Dey, G. Screening of yeast strains for vinification of fruits from cold desert regions of North West India. Int. Food Res. J. 2013, 20, 975–979. [Google Scholar]
- Luong, J.H.T. Kinetics of ethanol inhibition in alcohol fermentation. Biotechnol. Bioeng. 1985, 27, 280–285. [Google Scholar] [CrossRef]
- Kumar, S.; Singh, S.P.; Mishra, I.M.; Adhikari, D.K. Ethanol and xylitol production from glucose and xylose at high temperature by Kluyveromyces sp. IIPE453. J. Ind. Microbiol. Biotechnol. 2009, 36, 1483–1489. [Google Scholar] [CrossRef]
- Ndubuisi, I.A.; Qin, Q.; Liao, G.; Wang, B.; Moneke, A.N.; Ogbonna, J.C.; Jin, C.; Fang, W. Effects of various inhibitory substances and immobilization on ethanol production efficiency of a thermotolerant Pichia kudriavzevii. Biotechnol. Biofuels 2020, 13, 91. [Google Scholar] [CrossRef]
- Phong, H.X.; Klanrit, P.; Dung, N.; Thanonkeo, S.; Yamada, M.; Thanonkeo, P. High-temperature ethanol fermentation from pineapple waste hydrolysate and gene expression analysis of thermotolerant yeast Saccharomyces cerevisiae. Sci. Rep. 2022, 12, 13965. [Google Scholar] [CrossRef]
- Lin, Y.; Zhang, W.; Li, C.; Sakakibara, K.; Tanaka, S.; Kong, H. Factors affecting ethanol fermentation using Saccharomyces cerevisiae BY4742. Biomass Bioenergy 2012, 47, 395–401. [Google Scholar] [CrossRef]
- Limtong, S.; Sringiew, C.; Yongmanitchai, W. Production of fuel ethanol at high temperature from sugar cane juice by a newly isolated Kluyveromyces marxianus. Bioresour. Technol. 2007, 98, 3367–3374. [Google Scholar] [CrossRef]
- Mitova, M.I.; Usov, A.I.; Bilan, M.I.; Stefanov, K.L.; Dimitrova-Konaklieva, S.D.; Tonov, D.P.; Popov, S.S. Sterols and Polysaccharides in Freshwater Algae Spirogyra and Mougeotia. Z. Naturforschung C 1999, 54, 1016–1020. [Google Scholar] [CrossRef]
- Rodrussamee, N.; Lertwattanasakul, N.; Hirata, K.; Suprayogi; Limtong, S.; Kosaka, T.; Yamada, M. Growth and ethanol fermentation ability on hexose and pentose sugars and glucose effect under various conditions in thermotolerant yeast Kluyveromyces marxianus. Appl. Microbiol. Biotechnol. 2011, 90, 1573–1586. [Google Scholar] [CrossRef]
- Díaz-Nava, L.E.; Montes-Garcia, N.; Domínguez, J.M.; Aguilar-Uscanga, M.G. Effect of carbon sources on the growth and ethanol production of native yeast Pichia kudriavzevii ITV-S42 isolated from sweet sorghum juice. Bioprocess Biosyst. Eng. 2017, 40, 1069–1077. [Google Scholar] [CrossRef]
- Talukder, A.A.; Adnan, N.; Siddiqa, A.; Miah, R.; Tuli, J.F.; Khan, S.T.; Dey, S.K.; Lertwattanasakul, N.; Yamada, M. Fuel ethanol production using xylose assimilating and high ethanol producing thermosensitive Saccharomyces cerevisiae isolated from date palm juice in Bangladesh. Biocatal. Agric. Biotechnol. 2019, 18, 101029. [Google Scholar] [CrossRef]
- Nweze, J.E.; Ndubuisi, I.; Murata, Y.; Omae, H.; Ogbonna, J.C. Isolation and evaluation of xylose-fermenting thermotolerant yeasts for bioethanol production. Biofuels 2019, 12, 1–10. [Google Scholar] [CrossRef]
- Bruinenberg, P.M.; de Bot, P.H.M.; van Dijken, J.P.; Scheffers, W.A. NADH-linked aldose reductase: The key to anaerobic alcoholic fermentation of xylose by yeasts. Appl. Microbiol. Biotechnol. 1984, 19, 256–260. [Google Scholar] [CrossRef]
- Hahn-Hägerdal, B.; Jeppsson, H.; Olsson, L.; Mohagheghi, A. An interlaboratory comparison of the performance of ethanol-producing micro-organisms in a xylose-rich acid hydrolysate. Appl. Microbiol. Biotechnol. 1994, 41, 62–72. [Google Scholar]
- Rahman, K.H.A.; Najimudin, N.; Ismail, K.S.K. Transcriptomes analysis of Pichia kudriavzevii UniMAP 3-1 in response to acetic acid supplementation in glucose and xylose medium at elevated fermentation temperature. Process Biochem. 2022, 118, 41–51. [Google Scholar] [CrossRef]
- Jojima, T.; Omumasaba, C.A.; Inui, M.; Yukawa, H. Sugar transporters in efficient utilization of mixed sugar substrates: Current knowledge and outlook. Appl. Microbiol. Biotechnol. 2009, 85, 471–480. [Google Scholar] [CrossRef]
- Bertilsson, M.; Andersson, J.; Lidén, G. Modeling simultaneous glucose and xylose uptake in Saccharomyces cerevisiae from kinetics and gene expression of sugar transporters. Bioprocess Biosyst. Eng. 2008, 31, 369–377. [Google Scholar] [CrossRef]
- Diderich, J.A.; Schepper, M.; van Hoek, P.; Luttik, M.A.H.; van Dijken, J.P.; Pronk, J.T.; Klaassen, P.; Boenlens, H.F.M.; de Mattos, M.J.T.; van Dam, K.; et al. Glucose Uptake Kinetics and Transcription of HXT Genes in Chemostat Cultures of Saccharomyces cerevisiae. J. Biol. Chem. 1999, 274, 15350–15359. [Google Scholar] [CrossRef] [PubMed]
- Khammee, P.; Ramaraj, R.; Whangchai, N.; Bhuyar, P.; Unpaprom, Y. The immobilization of yeast for fermentation of macroalgae Rhizoclonium sp. for efficient conversion into bioethanol. Biomass Convers. Biorefin. 2020, 11, 827–835. [Google Scholar] [CrossRef]
- Jeyakumar, N.; Hoang, A.T.; Nižetić, S.; Balasubramanian, D.; Kamaraj, S.; Pandian, P.L.; Sirohi, R.; Nguyen, P.Q.P.; Nguyen, X.P. Experimental investigation on simultaneous production of bioethanol and biodiesel from macro-algae. Fuel 2022, 329, 125362. [Google Scholar] [CrossRef]
- Wang, L.-Q.; Cai, L.-Y.; Ma, Y.-L. Study on inhibitors from acid pretreatment of corn stalk on ethanol fermentation by alcohol yeast. RSC Adv. 2020, 10, 38409–38415. [Google Scholar] [CrossRef] [PubMed]
- Palma, M.; Guerreiro, J.F.; Sá-Correia, I. Adaptive Response and Tolerance to Acetic Acid in Saccharomyces cerevisiae and Zygosaccharomyces bailii: A Physiological Genomics Perspective. Front. Microbiol. 2018, 9, 274. [Google Scholar] [CrossRef]
- Favaro, L.; Basaglia, M.; Trento, A.; Van Rensburg, E.; García-Aparicio, M.; Van Zyl, W.H.; Casella, S. Exploring grape marc as trove for new thermotolerant and inhibitor-tolerant Saccharomyces cerevisiae strains for second-generation bioethanol production. Biotechnol. Biofuels 2013, 6, 168. [Google Scholar] [CrossRef]
- Pattanakittivorakul, S.; Lertwattanasakul, N.; Yamada, M.; Limtong, S. Selection of thermotolerant Saccharomyces cerevisiae for high temperature ethanol production from molasses and increasing ethanol production by strain improvement. Antonie Van Leeuwenhoek 2019, 112, 975–990. [Google Scholar] [CrossRef]
- Du, C.; Li, Y.; Zhao, X.; Pei, X.; Yuan, W.; Bai, F.; Jiang, Y. The production of ethanol from lignocellulosic biomass by Kluyveromyces marxianus CICC 1727-5 and Spathaspora passalidarum ATCC MYA-4345. Appl. Microbiol. Biotechnol. 2019, 103, 2845–2855. [Google Scholar] [CrossRef]
- Yuangsaard, N.; Yongmanitchai, W.; Yamada, M.; Limtong, S. Selection and characterization of a newly isolated thermotolerant Pichia kudriavzevii strain for ethanol production at high temperature from cassava starch hydrolysate. Antonie van Leeuwenhoek 2012, 103, 577–588. [Google Scholar] [CrossRef]
- Astuti, R.I.; Alifianti, S.; Maisyitoh, R.N.; Mubarik, N.R.; Meryandini, A. Ethanol Production by Novel Proline Accumulating Pichia kudriavzevii Mutants Strains Tolerant to High Temperature and Ethanol Stresses. OnLine J. Biol. Sci. 2018, 18, 349–357. [Google Scholar] [CrossRef]
- Murata, Y.; Nwuche, C.O.; Nweze, J.E.; Ndubuisi, I.A.; Ogbonna, J.C. Potentials of multi-stress tolerant yeasts, Saccharomyces cerevisiae and Pichia kudriavzevii for fuel ethanol production from industrial cassava wastes. Process Biochem. 2021, 111, 305–314. [Google Scholar] [CrossRef]

| Run | Sulfuric Acid (% v/v) | Biomass Loading (% w/v) | Reaction Time (min) | Total Sugar (g/L) |
|---|---|---|---|---|
| 1 | 3 | 6 | 10 | 12.2 |
| 2 | 3 | 8 | 15 | 14.0 |
| 3 | 2 | 4 | 20 | 8.4 |
| 4 | 1 | 8 | 15 | 12.0 |
| 5 | 3 | 4 | 15 | 7.8 |
| 6 | 2 | 6 | 15 | 11.6 |
| 7 | 2 | 6 | 15 | 11.4 |
| 8 | 1 | 6 | 20 | 11.1 |
| 9 | 1 | 4 | 15 | 7.4 |
| 10 | 3 | 6 | 20 | 12.1 |
| 11 | 2 | 6 | 15 | 11.3 |
| 12 | 2 | 4 | 10 | 8.2 |
| 13 | 2 | 8 | 20 | 14.9 |
| 14 | 1 | 6 | 10 | 10.0 |
| 15 | 2 | 8 | 10 | 14.1 |
| Source | Degree of Freedom | F-Value | p-Value |
|---|---|---|---|
| Model | 9 | 114.16 | <0.0001 |
| A—Acid | 1 | 53.39 | 0.0008 |
| B—Substrate | 1 | 906.45 | <0.0001 |
| C—Time | 1 | 5.68 | 0.0629 |
| AB | 1 | 8.17 | 0.0355 |
| AC | 1 | 4.83 | 0.0792 |
| BC | 1 | 1.74 | 0.2443 |
| A2 | 1 | 16.97 | 0.0092 |
| B2 | 1 | 15.55 | 0.0109 |
| C2 | 1 | 12.39 | 0.0169 |
| Lack of Fit | 3 | 9.34 | 0.0982 |
| Run | Glucose (g/L) | Xylose (g/L) | Arabinose (g/L) | Acetic Acid (g/L) |
|---|---|---|---|---|
| 1 | 4.79 ± 0.04 | 4.77 ± 0.07 | 1.74 ± 0.10 | 1.33 ± 0.25 |
| 2 | 5.40 ± 0.15 | 5.92 ± 0.19 | 2.14 ± 0.01 | 2.17 ± 0.47 |
| 3 | 3.19 ± 0.04 | 3.43 ± 0.17 | 1.29 ± 0.02 | 1.14 ± 0.26 |
| 4 | 4.21 ± 0.01 | 5.15 ± 0.01 | 2.17 ± 0.06 | 3.28 ± 0.12 |
| 5 | 2.97 ± 0.08 | 3.18 ± 0.23 | 1.14 ± 0.10 | 1.06 ± 0.39 |
| 6 | 4.54 ± 0.02 | 4.88 ± 0.00 | 1.83 ± 0.04 | 0.93 ± 0.04 |
| 7 | 4.51 ± 0.00 | 4.80 ± 0.01 | 1.82 ± 0.00 | 1.18 ± 0.01 |
| 8 | 3.93 ± 0.55 | 4.60 ± 0.04 | 1.83 ± 0.10 | 0.52 ± 0.06 |
| 9 | 2.66 ± 0.01 | 3.11 ± 0.08 | 1.26 ± 0.03 | 0.36 ± 0.04 |
| 10 | 4.65 ± 0.11 | 5.02 ± 0.25 | 1.84 ± 0.04 | 1.89 ± 0.43 |
| 11 | 4.35 ± 0.06 | 4.88 ± 0.40 | 1.79 ± 0.11 | 1.09 ± 0.36 |
| 12 | 3.13 ± 0.02 | 3.18 ± 0.00 | 1.22 ± 0.03 | 0.61 ± 0.87 |
| 13 | 5.80 ± 0.12 | 6.41 ± 0.30 | 2.37 ± 0.07 | 1.62 ± 0.47 |
| 14 | 3.50 ± 0.05 | 4.05 ± 0.08 | 1.71 ± 0.06 | 0.06 ± 0.00 |
| 15 | 5.25 ± 0.55 | 5.34 ± 0.76 | 1.88 ± 0.20 | 0.98 ± 0.03 |
| 16 * | 5.80 ± 0.82 | 6.00 ± 0.07 | 1.88 ± 0.20 | 0.30 ± 0.01 |
| Algae Species | Hydrolysis Conditions | Sugar Yield (g/g) | Inhibitor Yield (mg/g) | References |
|---|---|---|---|---|
| Green algae | ||||
| Spirogyra sp. and Oedogonium sp. | 121 °C, 180 min, 10% (v/v) HCL (25 g/250 mL) | 0.212 (RS) | 3.9 (LA), 7.9 (AA)), 0.15 (HMF) | [50] |
| 121 °C, 180 min, 10% (v/v) H2SO4 (25 g/250 mL) | 0.230 (RS) | 0.72 (LA), 4.2 (AA) | ||
| Spirogyra sp. | 121 °C, 60 min, 1 N H2SO4 (1 g/7.5 mL) | 0.363 (TS) | NR | [20] |
| Spirogyra sp. | 121 °C, 20 min, 2.67% (v/v) H2SO4 (2.39 g/30 mL) | 0.188 (TS), 0.073 (Glu), 0.075 (Xyl), 0.024 (Ara) | 3.76 (AA) | This study |
| Ulva fasciata | 121 °C, 20 min, 3% (v/v) H2SO4 | 0.700 (TS) | NR | [17] |
| Ulva lactuca | 121 °C, 90 min, 3.5% (v/v) H2SO4 | 29 mg/mL (RS) | NR | [43] |
| Ulva rigida | 121 °C, 60 min, 4% (v/v) H2SO4 (10%) | 0.319 (RS) | NR | [16] |
| Red algae | ||||
| Gracilaria verrucosa | 125 °C, 30 min, 0.1 N HCL (5%, 50 g/L) | 0.066 (Gal), 0.002 (Glu) | NR | [18] |
| 125 °C, 60 min, 0.1 N HCL (5%, 50 g/L) | 0.188 (Gal), 0.025 (Glu) | NR | ||
| 125 °C, 30 min, 0.1 N HCL (10%, 100 g/L) | 0.065 (Gal), 0.004 (Glu) | NR | ||
| 125 °C, 60 min, 0.1 N HCL (10%, 100 g/L) | 8.7 (HMF) | |||
| Gracilaria corticate var corticate | 121 °C, 15 min, 1% (v/v) H2SO4 (0.2 g/10 mL) | 0.130 (TS) | NR | [38] |
| Eucheuma spinosum | 121 °C, 70 min, 16.56% (v/v) H2SO4 (10 g/70 mL) | 0.30 g/L (RS) | NR | [19] |
| Yeast Strains | 37 °C | 40 °C | ||||
|---|---|---|---|---|---|---|
| P | Yp/s | Qp | P | Yp/s | Qp | |
| S. cerevisiae DBKKU Y-53 | 4.05 ± 0.35 a | 0.32 ± 0.04 b | 0.11 ± 0.01 a | 1.07 ± 0.47 b | 0.30 ± 0.01 b | 0.02 ± 0.01 b |
| K. marxianus DBKKU Y-102 | 4.48 ± 0.13 a | 0.33 ± 0.02 ab | 0.13 ± 0.00 a | 3.93 ± 0.24 a | 0.31 ± 0.01 b | 0.11 ± 0.01 a |
| P. kudriazevii RZ8-1 | 4.47 ± 0.19 a | 0.36 ± 0.03 a | 0.12 ± 0.01 a | 3.97 ± 0.19 a | 0.32 ± 0.01 ab | 0.11 ± 0.01a |
| Sugars and Acetic Acid (g/L) | S. cerevisiae DBKKU Y-53 | K. marxianus DBKKU Y-102 | P. kudriazevii RZ8-1 | ||||||
|---|---|---|---|---|---|---|---|---|---|
| 0 h | 48 h | Consumption | 0 h | 48 h | Consumption | 0 h | 48 h | Consumption | |
| 37 °C | |||||||||
| Glucose | 7.50 ± 0.11 | 0.44 ± 0.07 | 7.06 ± 0.18 a | 7.49 ± 0.20 | 0.17 ± 0.29 | 7.33 ± 0.45 a | 7.16 ± 0.14 | 0.38 ± 0.01 | 6.77 ± 0.14 a |
| Xylose | 7.45 ± 0.21 | 2.02 ± 0.08 | 5.43 ± 0.22 a | 7.26 ± 0.17 | 1.49 ± 0.12 | 5.77 ± 0.22 a | 7.01 ± 0.18 | 1.56 ± 0.12 | 5.45 ± 0.30 a |
| Arabinose | 2.48 ± 0.07 | 2.12 ± 0.05 | 0.36 ± 0.10 a | 2.36 ± 0.06 | 1.94 ± 0.08 | 0.44 ± 0.05 a | 2.35 ± 0.06 | 2.03 ± 0.14 | 0.21 ± 0.03 b |
| Acetic acid | 0.39 ± 0.01 | 0.43 ± 0.05 | - | 0.39 ± 0.01 | 0.91 ± 0.09 | - | 0.38 ± 0.02 | 0.91 ± 0.16 | - |
| 40 °C | |||||||||
| Glucose | 7.43 ± 0.25 | 5.08 ± 0.69 | 3.11 ± 1.56 b | 6.96 ± 0.24 | 0.27 ± 0.02 | 6.77 ± 0.22 a | 6.72 ± 0.27 | 0.20 ± 0.17 | 6.66 ± 0.16 a |
| Xylose | 7.50 ± 0.20 | 7.16 ± 0.25 | 0.33 ± 0.08 b | 7.29 ± 0.21 | 1.60 ± 0.10 | 5.68 ± 0.16 a | 7.12 ± 0.34 | 1.73 ± 0.59 | 5.39 ± 0.28 a |
| Arabinose | 2.26 ± 0.10 | 2.13 ± 0.07 | 0.13 ± 0.03 b | 2.18 ± 0.05 | 1.82 ± 0.08 | 0.36 ± 0.04 a | 2.12 ± 0.9 | 1.87 ± 0.24 | 0.25 ± 0.15 ab |
| Acetic acid | 0.93 ± 0.09 | 0.85 ± 0.04 | - | 0.87 ± 0.06 | 0.77 ± 0.07 | - | 0.83 ± 0.03 | 0.63 ± 0.12 | - |
Disclaimer/Publisher’s Note: The statements, opinions and data contained in all publications are solely those of the individual author(s) and contributor(s) and not of MDPI and/or the editor(s). MDPI and/or the editor(s) disclaim responsibility for any injury to people or property resulting from any ideas, methods, instructions or products referred to in the content. |
© 2023 by the authors. Licensee MDPI, Basel, Switzerland. This article is an open access article distributed under the terms and conditions of the Creative Commons Attribution (CC BY) license (https://creativecommons.org/licenses/by/4.0/).
Share and Cite
Vichit, S.; Salakkam, A.; Fiala, K. Exploring the Utilization Potential of Spirogyra sp. Biomass for Ethanol Production: A Study on Saccharification Optimization and High-Temperature Ethanol Fermentation. Processes 2023, 11, 2920. https://doi.org/10.3390/pr11102920
Vichit S, Salakkam A, Fiala K. Exploring the Utilization Potential of Spirogyra sp. Biomass for Ethanol Production: A Study on Saccharification Optimization and High-Temperature Ethanol Fermentation. Processes. 2023; 11(10):2920. https://doi.org/10.3390/pr11102920
Chicago/Turabian StyleVichit, Supachanee, Apilak Salakkam, and Khanittha Fiala. 2023. "Exploring the Utilization Potential of Spirogyra sp. Biomass for Ethanol Production: A Study on Saccharification Optimization and High-Temperature Ethanol Fermentation" Processes 11, no. 10: 2920. https://doi.org/10.3390/pr11102920
APA StyleVichit, S., Salakkam, A., & Fiala, K. (2023). Exploring the Utilization Potential of Spirogyra sp. Biomass for Ethanol Production: A Study on Saccharification Optimization and High-Temperature Ethanol Fermentation. Processes, 11(10), 2920. https://doi.org/10.3390/pr11102920

